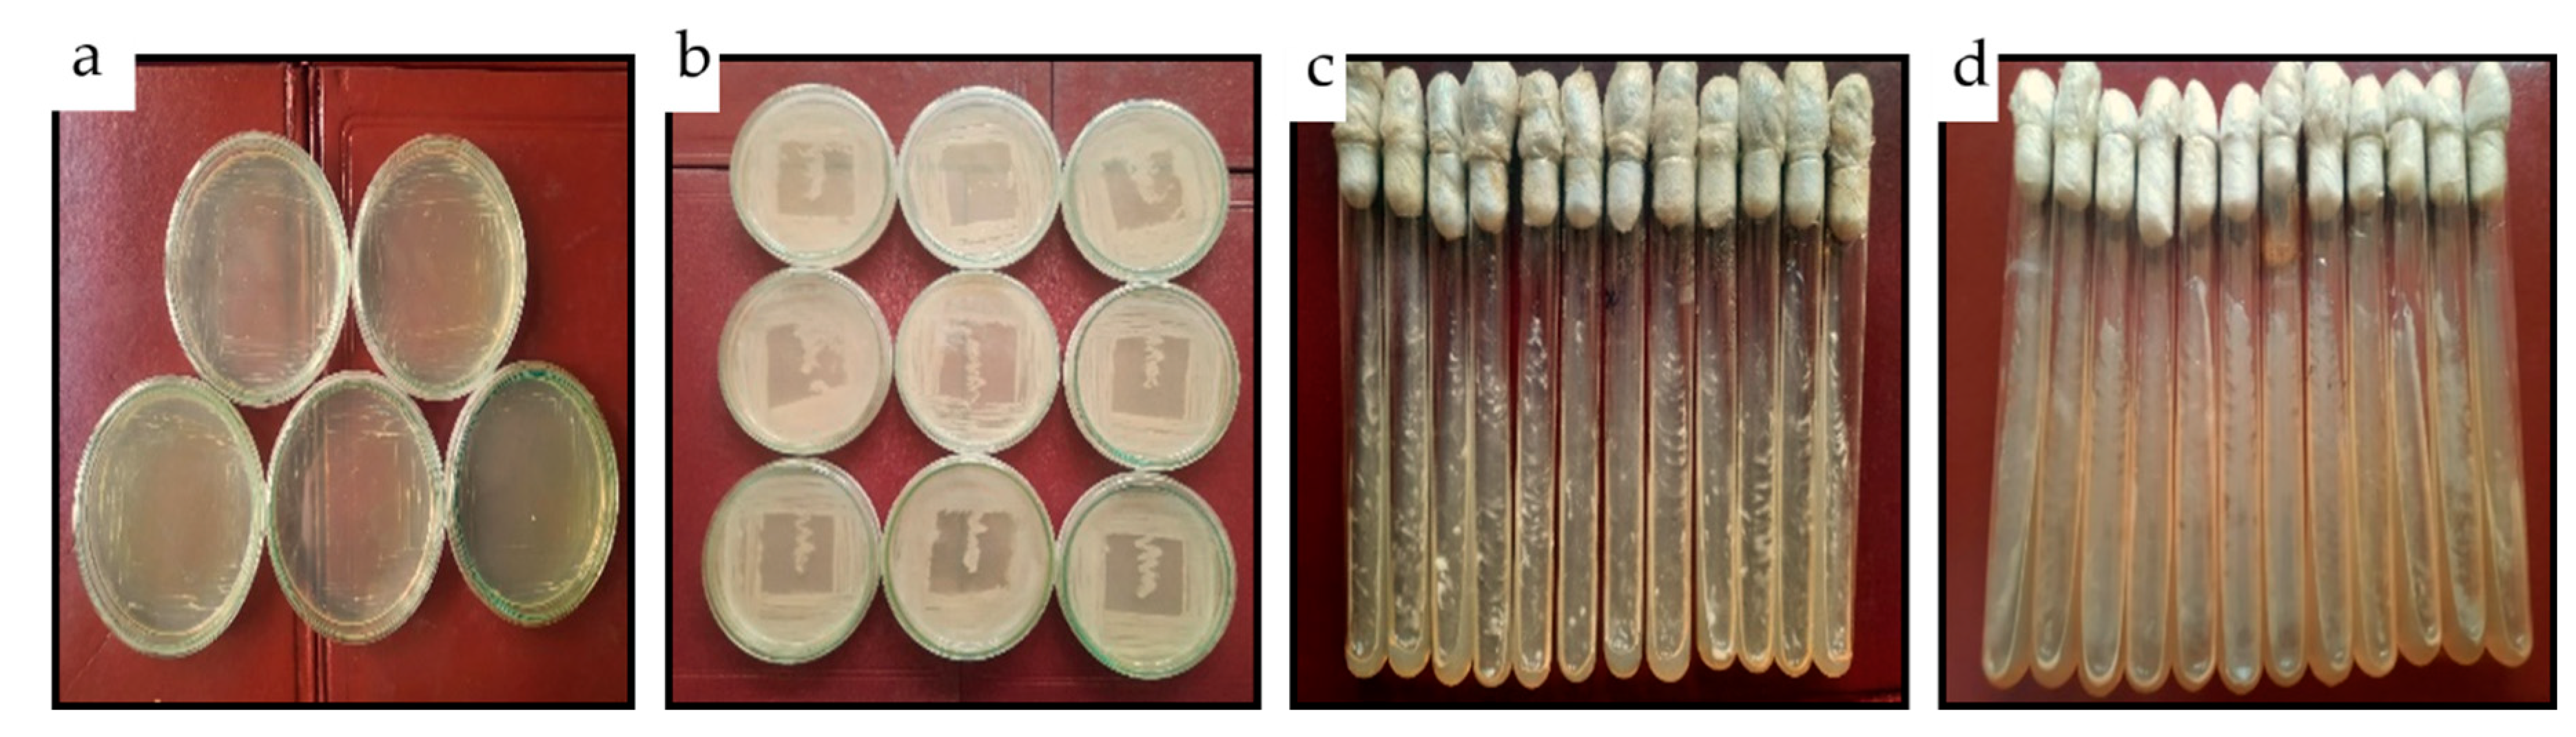
Water 15 03149 g001

Abstract
The increasing human population continues to exert pressure on the freshwater scarcity. The availability of freshwater for crop irrigation has become challenging. The present study aimed to use domestic wastewater (DWW) for the irrigation of two rice cultivars (CVs) after treatment with the bacterial strain Alcaligenes faecalis MT477813 under a hydroponic culture system. The first part of this study focused on the bioremediation and analysis of the physicochemical parameters of DWW to compare pollutants before and after treatment. The biotreatment of DWW with the bacterial isolate showed more than 90% decolourisation, along with a reduction in contaminants. The next part of the study evaluated the impacts of treated and untreated DWW on the growth of two rice cultivars, i.e., PK 386 and Basmati 515, under a hydroponic culture system which provided nutrients and water to plants with equal and higher yields compared to soil. Growth parameters such as the shoot and root length and the wet and dry weights of the rice plants grown in the treated DWW were considerably higher than those for the plants grown in untreated DWW. Therefore, enhanced growth of both rice cultivars grown in biotreated DWW was observed. These results demonstrate the bioremediation efficiency of the bacterial isolate and the utility of the DWW for rice crop irrigation subsequent to biotreatment.
1. Introduction
The growing population, urbanisation, industrialisation, agriculture and the lack of water management collectively exert stress on the freshwater supply. Therefore, the demand for water supply is increasing because of rapid growth in all the aforementioned areas [1]. Pakistan, as an agricultural and industrial country, has been ranked third in the list of the most water-scarce countries [2]. Moreover, the Pakistan Council of Research in Water Resources stated that the country would run short of clean, drinkable water before 2030 [3]. These circumstances necessitate the pursuit of alternate water resources as an essential requirement to meet the rapidly increasing demand for fresh water [4].
Domestic wastewater has long been considered an important alternative source of irrigation water and is utilised for irrigation in agriculture [5,6,7]. The wastewater is directly utilised for agriculture all over the country, near towns/municipalities with populations of more than 10,000 people [8]. Domestic wastewater typically includes organic matter and various important nutrients (N, K, P, Ca, Mn, S, Cu, Zn, Mn) that support agriculture by enhancing crop output as well as food quality [6]. Along with nutrients, domestic wastewater carries hazardous toxins, which may accumulate in agricultural plants. These nutrients and heavy metals, like cadmium, copper, iron, lead, nickel or zinc, induce phytotoxicity and pose a menace to human beings and other animals [9]. Local communities reuse raw wastewater to irrigate crops, which can be very detrimental to animal life, including humans [10,11,12,13]. The bioremediation of domestic wastewater with microbes has been considered an excellent biological activity due to metabolic activities of microorganisms such as bacteria [14,15,16], and their biological activity and metabolic flexibility might be tremendously advantageous in the conversion and degradation of harmful contaminants into non-toxic compounds [17]. A number of indigenous bacteria have the potential to discolour, detoxify and degrade the pollutants of different types of wastewater [16].
Rice is Pakistan’s second most important cash crop and requires abundant irrigation water throughout its growing period [18,19,20,21]. Due to water scarcity, farmers are compelled to use wastewater for crop irrigation. Out of the various types of wastewater, domestic wastewater may be utilised to irrigate these paddy fields. As domestic wastewater contains nutrients, organic matter, a high biological oxygen demand (BOD) value and many contaminants [22,23,24,25], its application for rice irrigation without adequate biotreatment has proven to be damaging to rice plants [13]. After appropriate biotreatment, wastewater can be utilised for mass production of nutritious rice crops [23,25,26,27].
Rice crops require excessive amounts of water, which is a challenge that appears daunting for farmers in water-scarce nations. [28]. Therefore, biotreated domestic wastewater may be used in hydroponic systems, as these systems assist in the early maturation of seedlings, provide higher crop yield, use 95% less water than usual irrigation and cope with late rainfall due to the changing climate [29]. This kind of hydroponic system also avoids the risks associated with soil diseases and salinity and waterlogging issues [30]. Some previous studies have asserted that biotreated domestic wastewaters lack certain nutrients up to the desired levels for crop growth; therefore, a hydroponic system needs additional ingredients to acquire quality-oriented rice production [31,32,33,34,35,36,37,38,39]. Researchers have also designated the Hoagland solution as a promising culture for hydroponic systems to grow different crops like wheat [31,32,33], tomatoes [34,35], lettuce [36,37], Arabidopsis [38] and onions [39].
Considering the aforementioned factors, the objectives of this work were to decolourise and degrade harmful contaminants in DWW using the bacterial isolate Alcaligenes faecalis MT477813. Also, this work compares the effect of untreated and biotreated domestic wastewater on the growth of rice cultivars (PK 386 and Basmati 515) in a hydroponic culture system to obtain sustainable agricultural output.
2. Materials and Methods
2.1. Collection and Characterisation of Domestic Wastewater
According to the APHA (2002) standard procedure [40], domestic wastewater was collected from the main point of discharge at Mohni Road, adjacent to Band Road, Lahore. The wastewater sample was screened for visible contaminants in the research lab at the Centre of Environmental Protection Studies, Pakistan Council of Scientific and Industrial Research, Lahore. The physicochemical parameters of the domestic wastewater (in four different treatments) such as the BOD, biodegradability index (BI), chemical oxygen demand (COD), colour, dissolved oxygen (DO), electrical conductivity (EC), heavy metal quantification (Zinc—Zn, Manganese—Mn and Iron—Fe) and NPK estimation, odour, pH, salinity, temperature, total suspended solids (TSSs), total dissolved solids (TDSs) and turbidity, were analysed pre- and post-biotreatment according to the standard methods of APHA [40] using a pH meter (Extech pH100, Nashua, NH, USA), an EC meter (Extech EC300, Nashua, NH, USA), a DO meter (Extech DO200, Nashua, NH, USA), BOD (Lovibond BOD5+, USA) and COD digesters (Merck COD digester T320, Darmstadt, Germany), a turbidity meter (Extech TB400, Nashua, NH, USA) and an atomic absorption spectrophotometer (AA 7000 F, Shimazdu Corporation, Kyoto, Honshu, Japan). These parameters were then compared with the National Environmental Quality Standard values [41] to assess the efficiency of the treatment.
2.2. Source of Alcaligenes Faecalis MT477813 Culture
The bacterial strain A. faecalis MT477813 was acquired from the Plant Biotechnology Lab, Botany Department, GC University Lahore. The strain was used to decolourise DWW because it had a bioremediation efficiency of more than 90% [15]. Initially, the strain was grown and streaked on plates containing solidified nutrient agar medium (Figure 1a). These plates were incubated at 37 °C for 24 h and colonies were prepared (Figure 1b). The LB (Lysogeny broth) agar slants were used to store the pure bacterial culture (Figure 1c,d) while keeping it at a temperature of 4 °C in a refrigerator [42].
Figure 1.
Culture of bacterial strain; (a) streaking of bacterial strain (A. faecalis MT477813) on NB plates, (b) bacterial growth on plates, (c) bacterial streaking on agar slants, and (d) bacterial growth on agar slants.
2.3. Domestic Wastewater Treatment
The decolourisation potential of A. faecalis MT477813 was tested at the following optimal conditions: duration (48 h), inoculum (10%) and temperature (37 °C) [14,15]. Each conical flask (250 mL) was inoculated with 10% bacterial strain solution (10 mL) in autoclaved domestic wastewater (90 mL). For the bacterial strain solution preparation, an inoculum loop full of bacterial colony was taken from slant and added to distilled water (100 mL). The optical density (OD) of 1 at 545 nm was achieved (A and E Labmed, AE-S80) to ensure an equal concentration of bacterial cells in each inoculum. The flasks having wastewater after inoculation were placed in a shaking incubator (PMI Labortechnik GMBH, WIS-20R) for 48 h at 37 °C and 120 rpm [43]. The decolourisation percentage was computed by Equation (1):
All decolourisation experiments were carried out in triplicates.
2.4. Germination of Rice Seedlings for Hydroponic Cultures
Two rice cultivars under the names PK 386 and Basmati 515 were obtained from the Rice Research Centre, Kala Shah Kaku, Pakistan [44]. The characteristic profile of these two cultivars is provided in Table 1. Chemicals used in this experiment were procured from “Thermo Fisher Scientific USA”, through “Worldwide Scientific” Syed Plaza, 30 Lahore—Kasur Rd, Jinnah Town, Lahore, Punjab, Pakistan.
Table 1.
Characteristic profile of rice cultivars data taken from [44].
Viable seeds of both rice CVs were selected for germination and surface sterilization of seeds was carried out using chemical treatment. Seeds were washed with tap water and treated with 70% ethanol solution for 40 s and with 30% sodium hypochlorite solution (added with a few drops of Tween20) for 3 min stepwise. The seeds were thoroughly washed with sterile distilled water after each chemical treatment. Under aseptic conditions, the sterile seeds were placed at equal spacing in Petri plates on filter paper (Whatman filter paper 42 having pore size of 2.5 μM) soaked with 5 mL autoclaved distilled water. Five sets of replicates were made for each cultivar. The plates were placed in growth room for seed germination under continuous fluorescent light at 26 °C ± 1 for 15 days (Figure 2).
Figure 2.
Germination of rice seeds on filter paper; seedlings of 15 days: (a) PK 386, (b) Basmati 515.
Hoagland solution [45] was prepared as nutrient medium for hydroponic growth of rice seedlings of both cultivars. The hydroponic culture system was designed using 1 L glass beakers. Each beaker possessed a piece of spherical recycled foam sheet one-inch-thick as a floater. Five holes of equal size were made to accommodate seedlings (each hole containing one seedling). Five sets of triplicates (1 L beaker each) were prepared under aseptic conditions; each set of replicates contained 500 mL of water types presented in Table 2.
Table 2.
Types of treatments and their composition.
2.5. Transfer of Seedlings to Hydroponic Cultures
Fifteen day old rice seedlings germinated in Petri plates were transplanted to 500 mL liquid nutrient medium in 1 L beakers under aseptic conditions. Rice seedlings were planted in the holes, being one seedling in each hole; roots passing through the hole were submerged in hydroponic culture medium and shoot exposed above the floater sheet (Figure 3). Seedlings of both rice cultivars were uniformly transplanted across all five sets of treatments in triplicates, as previously specified.
Figure 3.
Rice seedlings in hydroponic culture; (a) Control, (b) Treatment 1, (c) Treatment 2, (d) Treatment 3, (e) Treatment 4.
2.6. Growth of Seedlings and Analysis in Hydroponic Cultures
Beakers were wrapped in thick black polyethylene sheets with the exposed surface wrapped with a transparent PVC plastic sheet containing small holes to ensure the smooth acclimatization of seedlings. Beakers were placed in a growth room under 16/8 light/dark 24 h cycle at 26 °C ± 1. The plants increased gradually and the polythene sheet was completely removed from the beakers after 1 week. The growth experiment continued for 21 days. The plants were harvested after a growth period of 21 days and morphological growth parameters of the plants such as seedling length, shoot length, root length, wet and dry weight of seedling, shoot and root were recorded for each treatment.
2.7. Statistical Analyses
The data were analysed using SPSS as mean of triplicates ±SD (standard deviation) and comparisons of variance. Data values of different replicates and treatments were compared by One-Way ANOVA and t-test was run with two-tailed p-value to assess the magnitude of differences of corresponding means of four different treatments. These differences were only considered significant when p-values were <0.05.
3. Results and Discussion
3.1. Physiochemical Characterisation of Treatments
Physiochemical characterisation of the treatments revealed that values of all parameters before treatment (UTDWW) such as EC (973 μs/cm), BOD (295.7 mg/L), COD (412.8 mg/L), pH (8.5), turbidity (38.5 NTU), TSS (383 mg/L), TDS (730 mg/L) and salinity (0.43 ppt) decreased significantly after treatment (Table 3). Results showed that the values of various physicochemical parameters were within the levels of the National Environment Quality Standards (NEQS) after treatment with a Hoagland solution. For instance, the value of TSS was 930 mg/L in untreated domestic wastewater. The NEQS value for TSS was 500 mg/L. After biotreatment, the TSS value reduced to 300 mg/L and with an additional Hoagland solution, the value reduced to 298 mg/L. Similarly, turbidity reduced from 38.5 NTU to 18.3 NTU in biotreated domestic wastewater and then to 4.2 NTU in biotreated domestic wastewater with the addition of the Hoagland solution. The values of BOD and COD also reduced from 295.7 mg/L and 412.8 mg/L to 171.5 mg/L and 140 mg/L while their NEQS ranges were 80–250 mg/L and 150–400 mg/L, respectively. Other reduced physicochemical parameters including EC, TDS, salinity, pH, N, P, K, Zn, Mn and Fe also agree well with a previous research treating DWW with Alcaligenes faecalis MT477813 [41] and with our previous work [14,15].
Table 3.
The physicochemical characterisation of different treatments.
In our study, A. faecalis strain MT477813 led to the decolourisation percentage above 90%. A. faecalis has been also reported as a biocontrol agent [46,47] that may explain the reason BOD values reduced in all the treatments. Previously, the physiochemical analysis of biotreated and untreated domestic wastewater samples (without Hoagland solution) revealed a reduction (40–70%) in the peak intensities of many unwanted compounds, which have been shown to be harmful like phenol (876 µg/L), caffeine (7 µg/L), salicylic acid (48 µg/L), naproxen (23 µg/L), diazepam (14 µg/L) and octadecene (185 µg/L) [14,15,48,49,50,51,52]. However, in our work, the implementation of Hoagland’s solution treatments resulted in a decrease in these parameters by over 80%. Drawing upon prior research [14,15], it is conceivable that this amplified percentage reduction stemmed from the implementation of the Hoagland solution. In contrast, in our earlier studies (without the application of Hoagland solution), the diminution in physicochemical parameter values was comparatively milder (ranging from 40% to 70%). The comparison of all four treatments shows the following order in terms of treatment efficiency: Treatment 2 > Treatment 4 > Treatment 1 > Treatment 3. Here, Treatment 2 contains treated DWW with Hoagland solution which highlights higher treatment efficacy of A. faecalis with the Hoagland solution. Other scientists have also designated the Hoagland solution as a promising solution for a hydroponic culture system to grow different crops like wheat [31,32,33], tomatoes [34,35], lettuce [36,37], Arabidopsis [38] and onion [39].
3.2. Growth Parameters of Rice Cultivars in Different Hydroponic Treatments
Growth parameters were assessed under different treatments for both rice cultivars. Higher values were seen mainly in biotreated domestic wastewater with the Hoagland solution (Treatment 2) and the treatment efficiencies of both rice cultivars were compared (Figure 4a–c). The shoot length of both cultivars was observed to be the highest (14.5 and 18.3 cm) in Treatment 2 (TDWWH) as compared to other treatments of cultivar PK386 (13.8, 10.6 and 10.1 cm), BP515 (16.2, 14.8 and 13.7 cm) as well as the control (12.5 and 15.6 cm). Moreover, it was concluded from these readings that the treatment UTDWW has a negative impact, even with the Hoagland solution. This may be due to the presence of toxic compounds in domestic wastewater that overshadowed the benefits of the Hoagland solution [53]. Previous studies have also shown reduction in seedling length (mainly root length) as compared to the control when grown in raw wastewater mixed with the Hoagland solution in a hydroponic system [31,33,36,37,38,39].
Figure 4.
Comparison between Basmati 515 and PK386 under different treatments for morphological parameters: (a) seedling length, (b) shoot length, and (c) root length.
Comparison between Basmati 515 and PK386 under different treatments for morphological parameters, seedling length, shoot length, and root length showed that Basmati 515 performed better than PK386 in treatment 2 and 4 while PK386 gave better performance in treatment 3 and 1 as well as in the control (Figure 4). As treatments 1 and 3 were having untreated domestic wastewater, this implies that PK386 exhibit greater resilience to untreated wastewater, whereas Basmati 515 thrive in the presence of treated domestic wastewater, suggesting a higher level of sensitivity. This result is supported by the characteristic profile provided by the Rice Research Centre Kala Shah Kaku where Basmati 515 contains more N, P, K, iodine (I), Zn and Mn content compared to PK 386 (see Table 1) [44]. Hence, the resilience of PK386 is also attributed to the presence of macro- and micronutrients like N, P, K, I, Zn and Mn. Moreover, the projected yield for Basmati rice is estimated at 75 Maund per Acre, surpassing that of PK386 by 8%. This disparity further underscores the robustness of bananas in their growth [44]. This discrepancy not only highlights the strength of Basmati 515’s growth, but also reinforces their resilient role.
In hydroponic cultures, the average shoot and root weights of PK 386 (both dry and wet) were found to be higher in treatment 1 (UTDWWH) (shoot (dry weight: 0.018 g; wet weight: 0.282 g)); (root (dry weight: 0.009 g; wet weight: 0.141 g)) than the untreated DWW (shoot (dry weight: 0.0114 g; wet weight: 0.343 g)); (root (dry weight: 0.0057 g; wet weight: 0.217 g)), respectively (Table 4). This indicates three possibilities for the increased weight: (1) PK386 can grow well under stressed conditions [54]; (2) the weight was more due to toxic contaminants present in the untreated DWW [55]; and (3) the nutrients present in the Hoagland solution favoured the growth [55,56]. As far as the potential of the Hoagland solution is concerned, overall seedling wet weight was larger in treated DWW with the Hoagland solution than in untreated DWW with the Hoagland solution. This result agrees well with similar studies where total wet and dry weights of plants were more in those hydroponic cultures with Hoagland solution [57,58].
Table 4.
Morphological parameters of PK 386 in different hydroponic cultures.
In hydroponic cultures, the average shoot and root weights of Basmati 515 (both dry and wet) were found to be higher in bio treated DWW with Hoagland solution (shoot (dry weight: 0.012 g; wet weight: 0.138 g)); (root (dry weight: 0.0061 g; wet weight: 0.069 g)) than in the untreated DWW with Hoagland (Table 5). This shows the potential of Basmati 515 cultivar for domestic treated domestic wastewater and confirms the resilience of PK386 to toxic untreated domestic wastewater environment. Based upon previous research, two suppositions may be drawn from these observations: (1) A. faecalis led treated domestic wastewater with Hoagland solution is suitable for the Basmati 515 rice cultivar; and (2) PK386 has more potential to grow well under toxic conditions such as untreated DWW. Moreover, it is also evident that the Hoagland solution is nutrient-rich and adequate for hydroponic culture systems [57,58].
Table 5.
Morphological parameters of Basmati 515 in different hydroponic cultures.
Previous studies have found that saplings irrigated with untreated textile wastewater had shorter length and weight [59,60,61]. As far as the Hoagland solution is concerned, studies also endorsed its efficacy in synthesizing bacterial strains that may be helpful in the treatment of different wastewaters and assist in the growth of crop plants [53]. In our work, the Hoagland solution fulfilled the same purpose. The results of the hydroponic experiment were surprisingly significant. The impact of UTDWW and TDWW treatments (Treatments 1, 2, 3 and 4) on growth of the two rice cultivars under study indicated that the growth parameters under TDWW with the Hoagland solution were considerably higher than with only TDWW. Furthermore, UTDWW with or without the Hoagland solution demonstrated lower values of the growth parameters (Figure 4). A comparable pattern of seedling biomass (both wet and dry weights) was predominantly observed, with TDWWH, exhibiting the highest biomass levels (Table 4 and Table 5). The possible reasons for this increased biomass are two: (1) presence of organic matter and nutrients (N, K, P, Ca, Mn, S, Cu, Zn, Mn) in domestic wastewater [6] or (2) due to the presence of Hoagland solution [31,32,33,34,35,36,37,38,39].
4. Conclusions
Domestic wastewater irrigation tends to have a long past, passing through many stages in both high- and low-income countries, including Pakistan. Furthermore, farmers are compelled to use DWW for irrigation due to the scarcity of water. Irrigation by UTDWW has been reported to produce a number of environmental problems. The hazardous materials in wastewater promote chemical and biological changes in the environment, posing health risks to humans and ecosystems. Our study aimed to contribute to the approaches used to tackle hazardous pollutants in wastewater in order to make wastewater useful for irrigation. Biotreatment of DWW with A. faecalis MT477813 decreased the values of physicochemical parameters such as EC, BOD, COD, pH, temperature, turbidity, TSS, TDS, salinity, odour and colour. Biotreatment of DWW with the bacterial isolate showed more than 90% decolourisation along with reduction in contaminants. Upon germination under hydroponic culture system, PK386 and Basmati 515, growth parameters such as shoot and root length, wet and dry weights of rice plants grown in treatment 2 (TDWWH) were considerably higher than the plants grown in untreated DWW. The biotreatment of DWW in presence of Hoagland solution showed an increase in growth parameters such as shoot length of both rice cultivars. Overall, an enhanced growth of both cultivars grown in biotreated DWW with Hoagland solution was observed. The current study aligns with the perspective advocating for the utilization of indigenous bacterial populations to mitigate the impact of pollutants present in wastewater on living organisms. We recommend further research into the quality of fruit yield derived from these hydroponic systems.
Author Contributions
Conceptualization, T.A., S.A.M. and A.R.; methodology, A.R., S.A.M. and T.A.; software, A.R. and T.A.; validation, A.R., S.A.M., T.A., M.A.J. and L.C.C.; formal analysis, T.A. and A.R.; Investigation, T.A. and A.R.; resources, T.A., A.R., S.A.M. and M.A.J.; data curation, T.A. and A.R.; writing—original draft preparation, T.A.; writing—review and editing, T.A., A.R., S.A.M. and L.C.C.; visualization, A.R., S.A.M., T.A., M.A.J. and L.C.C.; supervision, S.A.M. and M.A.J.; project administration, A.R., S.A.M., T.A., M.A.J. and L.C.C.; funding acquisition, T.A. and A.R. All authors have read and agreed to the published version of the manuscript.
Funding
No external source of funding is involved.
Data Availability Statement
All relevant data are included in the paper.
Acknowledgments
Authors acknowledge the Department of Botany and GC University, Lahore for their support during the research work.
Conflicts of Interest
The authors declare no conflict of interest.
References
- Khoso, S.; Wagan, F.H.; Tunio, A.H.; Ansari, A.A. An overview on emerging water scarcity in Pakistan, its causes, impacts and remedial measures. J. Appl. Eng. Sci. 2015, 13, 38–40. [Google Scholar] [CrossRef]
- Nabi, G.; Ali, M.; Khan, S.; Kumar, S. The crisis of water shortage and pollution in Pakistan: Risk to public health, biodiversity, and ecosystem. Environ. Sci. Pollut. Res. 2019, 26, 10443–10445. [Google Scholar] [CrossRef] [PubMed]
- Shukla, V. Pakistan’s Alarming Water Crisis: Country to Run out of Clean Water by 2025. 2018. Available online: https://www.valuewalk.com/pakistan-water-crisis-clean-water-2025/ (accessed on 20 July 2023).
- Chung, S.O.; Rodríguez-Díaz, J.A.; Weatherhead, E.K.; Knox, J.W. Climate change impacts on water for irrigating paddy rice in South Korea. Irrig. Drain. 2011, 60, 263–273. [Google Scholar] [CrossRef]
- Zhang, Y.; Shen, Y. Wastewater irrigation: Past, present, and future. Wiley Interdiscip. Rev. Water 2019, 6, 1230–1234. [Google Scholar] [CrossRef]
- Gassama, U.M.; Puteh, A.B.; Abd-Halim, M.R.; Kargbo, B. Influence of municipal wastewater on rice seed germination, seedling performance, nutrient uptake, and chlorophyll content. J. Crop Sci. Biotechnol. 2015, 18, 9–19. [Google Scholar] [CrossRef]
- Singh, P.K.; Deshbhratar, P.B.; Ramteke, D.S. Effects of sewage wastewater irrigation on soil properties, crop yield and environment. Agric. Water Manag. 2012, 103, 100–104. [Google Scholar] [CrossRef]
- Khalil, S.; Kakar, M.K. Agricultural use of untreated urban wastewater in Pakistan. Asian J. Agric. Rural. Dev. 2011, 1, 21–26. [Google Scholar]
- Khawla, K.; Besma, K.; Enrique, M.; Mohamed, H. Accumulation of trace elements by corn (Zea mays) under irrigation with treated domestic wastewater using different irrigation methods. Ecotoxicol. Environ. Saf. 2019, 170, 530–537. [Google Scholar] [CrossRef]
- Khan, A.; Bruce, K. How residues of deinstitutionalised practices persist over time: World Bank boundary work in development projects in Pakistan from the 1970s to the mid-2000s. Bus. Hist. 2021, 4, 1–29. [Google Scholar] [CrossRef]
- Contreras, J.D.; Meza, R.; Siebe, C.; Rodríguez-Dozal, S.; López-Vidal, Y.A.; Castillo-Rojas, G.; Amieva, R.I.; Solano-Gálvez, S.G.; Mazari-Hiriart, M.; Silva-Magaña, M.A.; et al. Health risks from exposure to untreated domestic wastewater used for irrigation in the Mezquital Valley, Mexico: A 25-year update. Water Res. 2017, 123, 834–850. [Google Scholar] [CrossRef]
- Keraita, B.; Jimenez, B.; Drechsel, P. Extent and implications of agricultural reuse of untreated, partly treated and diluted wastewater in developing countries. CABI Rev. Perspect. Agric. Vet. Sci. Nutr. Nat. Resour. 2008, 3, 1–15. [Google Scholar] [CrossRef]
- Hamilton, A.J.; Stagnitti, F.; Xiong, X.; Kreidl, S.L.; Benke, K.K.; Maher, P. Wastewater irrigation: The state of play. Vadose Zone J. 2007, 6, 823–840. [Google Scholar] [CrossRef]
- Rashid, A.; Mirza, S.A.; Keating, C.; Ali, S.; Campos, L.C. Hospital wastewater treated with a novel bacterial consortium (Alcaligenes faecalis and Bacillus paramycoides spp.) for phytotoxicity reduction in Berseem clover and tomato crops. Water Sci. Technol. 2021, 83, 1764–1780. [Google Scholar] [CrossRef] [PubMed]
- Rashid, A.; Mirza, S.A.; Keating, C.; Ali, S.; Campos, L.C. Indigenous Bacillus paramycoides spp. and Alcaligenes faecalis: Sustainable solution for bioremediation of hospital wastewater. Environ. Technol. 2020, 43, 1903–1916. [Google Scholar] [CrossRef]
- Sonune, N.A.; Garode, A.M. Bioremediation potential of bacterial isolates for municipal wastewater treatment. Curr. World Environ. 2015, 10, 619–625. [Google Scholar] [CrossRef]
- Díaz, E. Genomic insights into the aerobic pathways for degradation of organic pollutants. In Microbial Biodegradation: Genomics and Molecular Biology, 1st ed.; McLeod, M.P., Eltis, L.D., Eds.; Caister Academic Press: Wymondham, UK, 2008; pp. 5–24. [Google Scholar]
- Nirmala, B. Rice production in Asia: Key to global food security. Proc. Natl. Acad. Sci. India Sect. B Biol. Sci. 2018, 88, 1323–1328. [Google Scholar]
- Rehman, A.; Jingdong, L.; Chandio, A.A.; Shabbir, M.; Hussain, I. Economic outlook of rice crops in Pakistan: A time series analysis (1970–2015). Financ. Innov. 2017, 3, 13. [Google Scholar] [CrossRef]
- Verma, A.K.; Dash, R.R.; Bhunia, P. A review on chemical coagulation/flocculation technologies for removal of colour from textile wastewaters. J. Environ. Manag. 2012, 93, 154–168. [Google Scholar] [CrossRef]
- Hai, F.I.; Yamamoto, K.; Fukushi, K. Hybrid treatment systems for dye wastewater. Crit. Rev. Environ. Sci. Technol. 2007, 37, 315–377. [Google Scholar] [CrossRef]
- Dash, A.K. Impact of domestic waste water on seed germination and physiological parameters of rice and wheat. Int. J. Recent Res. Appl. Stud. 2012, 12, 280–286. [Google Scholar]
- Li, L.; Yang, Y.; Tam, N.F.; Yang, L.; Mei, X.Q.; Yang, F.J. Growth characteristics of six wetland plants and their influences on domestic wastewater treatment efficiency. Ecol. Eng. 2013, 60, 382–392. [Google Scholar] [CrossRef]
- Singh, R.P.; Singh, P.; Kothari, R.; Gautam, K.; Singh, A. Application of Wastewater in Irrigation and Its Regulation with Special Reference to Agriculture Residues. In Water Pollution and Management Practices; Springer: Singapore, 2021; pp. 177–199. [Google Scholar]
- Tran, L.D.; Phung, L.D.; Pham, D.V.; Pham, D.D.; Nishiyama, M.; Sasaki, A.; Watanabe, T. High yield and nutritional quality of rice for animal feed achieved by continuous irrigation with treated municipal wastewater. Paddy Water Environ. 2019, 17, 507–513. [Google Scholar] [CrossRef]
- Fendri, I.; SBen, R.; Khemakhem, B.; Ben, H.N.; Gdoura, R.; Abdelkafi, S. Effect of treated and untreated domestic wastewater on seed germination, seedling growth and amylase and lipase activities in Avena sativa L. J. Sci. Food Agric. 2013, 93, 74–156. [Google Scholar] [CrossRef] [PubMed]
- Huy, V.; Iwai, C.B. Utilisation of wastewater on seed germination and physiological parameters of rice (Oryza sativa L.). IOP Conf. Ser. Mater. Sci. Eng. 2018, 334, 012036. [Google Scholar] [CrossRef]
- WWF. ‘Study: Growing More Rice with Less Water’. Available online: https://www.bing.com/search?q=rice+need+more+water+an+issue+to+water+scarce+countries&qs=n&form=QBRE&sp=-1&lq=0&pq=&sc=0-0&sk=&cvid=39E27064BE174AD092C4A449E8AA3B89&ghsh=0&ghacc=0&ghpl= (accessed on 28 August 2023).
- Hydroponics Rice Paddy Nursery: An Innovative Twist on Growing Rice in India, Rice Today. Available online: https://ricetoday.irri.org/hydroponics-rice-paddy-nursery-an-innovative-twist-on-growing-rice-in-india/#:~:text=The%20other%20advantages%20of%20hydroponics,Uses%2095%25%20less%20water (accessed on 28 August 2023).
- Johnson, L. Why Use Hydroponics? Available online: https://ezgrogarden.com/hydroponics/why-use-hydroponics/#:~:text=Hydroponics%20eliminates%20soil%20and%20soil,and%20streams%2C%20harming%20fish%20populations (accessed on 28 August 2023).
- Motuzas, J.; Drobek, M.; Martens, D.L.; Vallicari, C.; Julbe, A.; Diniz da Costa, J.C. Environmental mineralization of caffeine micro-pollutant by Fe-MFI zeolites. Environ. Sci. Pollut. Res. 2017, 25, 3628–3635. [Google Scholar] [CrossRef] [PubMed]
- Gushit, J.S.; Ekanem, E.O.; Adamu, H.M.; Chindo, I.Y. Analysis of herbicide residues and organic priority pollutants in selected root and leafy vegetable crops in Plateau state, Nigeria. World J. Anal. Chem. 2013, 1, 23–28. [Google Scholar]
- Wojcieszynska, D.; Domaradzka, D.; Hupert-Kocurek, K.; Guzik, U. Bacterial degradation of naproxen—Undisclosed pollutant in the environment. J. Environ. Manag. 2014, 145, 157–161. [Google Scholar] [CrossRef] [PubMed]
- Al Hamedi, F.; Karthishwaran, K.; Alyafei, M.A.M. Hydroponic wheat production using fresh water and treated domestic wastewater under the semi-arid region. Emir. J. Food Agric. 2021, 33, 178–186. [Google Scholar] [CrossRef]
- Ranjitha, K.M.; Biradar, S.S.; Desai, S.A.; Naik, V.R.; Bhat, S.; Satisha, T.N.; Hiremath, G.; Kumar, K.J.Y.; Chethana, C.K.; Venkatesh, K. Media standardization for hydroponic culture to screen wheat genotypes for nitrogen use efficiency. Int. J. Curr. Microbiol. App. Sci. 2017, 6, 2814–2820. [Google Scholar] [CrossRef]
- Mackowiak, C.L.; Owens, L.P.; Hinkie, C.R.; Kennedy Space Center, Florida. Continuous Hydroponic Wheat Production Using a Recirculating System; NASA John F. Kennedy Space Center: Merritt Island, FL, USA, 1989. [Google Scholar]
- Prazeres, A.R.; Albuquerque, A.; Luz, S.; Jeronimo, E.; Carvalho, F. Food Biosynthesis, In Hydroponic System: A Promising Biotechnology for Food Production and Wastewater Treatment; Elsevier Inc.: Amsterdam, The Netherlands, 2017. [Google Scholar] [CrossRef]
- Shah, A.H.; Munir, S.U.; Amin, N.U.; Shah, S.H. Evaluation of two nutrient solutions for growing tomatoes in a non-circulating hydroponics system. Sarhad J. Agric. 2011, 27, 557–567. [Google Scholar]
- Jesse, S.D. Treatment of Post Hydrothermal Liquefaction Wastewater and Suitability for Hydroponic Lettuce Production. Master’s Thesis, University of Illinois Urbana-Champaign, Champaign, IL, USA, 2019. [Google Scholar]
- APHA. Standard Methods for the Examination of Water and Wastewater, 21st ed.; American Public Health Association: Washington, DC, USA, 2002. [Google Scholar]
- National Environment Quality Standards (NEQS). The Gazette of Pakistan. Ministry of Environment, Local Government and Rural Development; Government of Pakistan: Islamabad, Pakistan, 2000; pp. 1289–1294.
- Mahmood, A.; Malik, R.N. Human health risk assessment of heavy metals via consumption of contaminated vegetables collected from different irrigation sources in Lahore, Pakistan. Arab. J. Chem. 2014, 7, 91–99. [Google Scholar] [CrossRef]
- Ajaz, M.; Rehman, A.; Khan, Z.; Nisar, M.A.; Hussain, S. Degradation of azo dyes by Alcaligenes aquatilis 3C and its potential use in the wastewater treatment. AMB Express 2019, 9, 64. [Google Scholar] [CrossRef] [PubMed]
- Rice Research Institute, Kala Shah Kaku. Ayub Agricultural Research Institute, Faisalabad. Available online: https://aari.punjab.gov.pk/crop_varities_rice (accessed on 24 July 2023).
- Hoagland, D.R.; Arnon, D.I. The water-culture method for growing plants without soil. Circular. Calif. Agric. Exp. Stn. 1950, 347, 117–139. [Google Scholar]
- Dwivedi, P.; Tomar, R.S. Bioremediation of textile effluent for degradation and decolourisation of synthetic dyes: A review. Int. J. Curr. Res. Life Sci. 2018, 7, 1948–1951. [Google Scholar]
- Yokoyama, S.I.; Adachi, Y.; Asakura, S.; Kohyama, E. Characterization of Alcaligenes faecalis strain AD15 indicating biocontrol activity against plant pathogens. J. Gen. Appl. Microbiol. 2013, 59, 89–95. [Google Scholar] [CrossRef] [PubMed]
- Rodil, R.; Quintana, J.B.; Concha-Grana, E.; Lopez-Mahia, P.; Muniategui-Lorenzo, S.; Prada-Rodriguez, D. Emerging pollutants in sewage, surface and drinking water in Galicia (NW Spain). Chemosphere 2012, 86, 1040–1049. [Google Scholar] [CrossRef]
- Meerbergen, K.; Willems, K.A.; Dewil, R.; Van Impe, J.; Appels, L.; Lievens, B. Isolation and screening of bacterial isolates from wastewater treatment plants to decolourise azo dyes. J. Biosci. Bioeng. 2018, 125, 448–456. [Google Scholar] [CrossRef]
- Spehia, R.S.; Devi, M.; Singh, J.; Sharma, S.; Negi, A.; Singh, S.; Chauhan, N.; Sharma, D.; Sharma, J.C. Lettuce growth and yield in hoagland solution with an organic concoction. Int. J. Veg. Sci. 2018, 24, 557–566. [Google Scholar] [CrossRef]
- Delden, S.H.; Nazarideljou, M.J.; Marcells, L.F.M. Nutrient solutions for Arabidopsis thaliana: A study on nutrient solution composition in hydroponics systems. Plant Methods 2020, 16, 72. [Google Scholar] [CrossRef]
- Kane, C.D. Influence of Nutrient Solution and Solution pH on Onion Growth and Mineral Content. Ph.D. Thesis, Texas Tech University, Lubbock, TX, USA, 2003. [Google Scholar]
- Shi, X.; Sun, H.; Pan, H.; Chen, Y.; Jiang, Z.; Liu, J.; Wang, S. Growth and efficiency of nutrient removal by Salix jiangsuensis J172 for phytoremediation of urban wastewater. Environ. Sci. Pollut. Res. 2016, 23, 2715–2723. [Google Scholar] [CrossRef]
- Saleem, A.; Zulfiqar, A.; Ali, B.; Naseeb, M.A.; Almasaudi, A.S.; Harakeh, S. Iron Sulfate (FeSO4) Improved physiological attributes and antioxidant capacity by reducing oxidative stress of Oryza sativa L. cultivars in alkaline soil. Sustainability 2022, 14, 16845. [Google Scholar] [CrossRef]
- Singh, R.P.; Agrawal, M. Variations in heavy metal accumulation, growth and yield of rice plants grown at different sewage sludge amendment rates. Ecotoxicol. Environ. Saf. 2010, 73, 632–641. [Google Scholar] [CrossRef]
- Kang, J.G.; Iersel, M.W. Nutrient Solution Concentration Affects Shoot: Root Ratio, Leaf Area Ratio, and Growth of Subirrigated Salvia (Salvia splendens). HortScience 2004, 39, 49–54. [Google Scholar] [CrossRef]
- Trejo-Téllez, L.I.; Gómez-Merino, F.C. Hydroponics—A Standard Methodology for Plant Biological Researches, In Nutrient Solutions for Hydroponic Systems; IntechOpen: London, UK, 2012. [Google Scholar]
- Amedi, J.; Rasheed, R.; Ibrahim, D. Responce of Physico-Chemical Soil Properties to Wastewater Application and Subsequent Effects on Three Woody Species Plants. J. Duhok Univ. 2021, 24, 106–125. [Google Scholar] [CrossRef]
- Rana, S.; Kumar, K. Study of phytotoxic effect of textile wastewater on seed germination and seedling growth of Triticum aestivum. Int. J. BioSci. Technol. 2017, 10, 58–66. [Google Scholar]
- Magwaza, S.T.; Magwaza, L.S.; Odindo, A.O.; Mditshwa, A. Hydroponic technology as decentralized system for domestic wastewater treatment and vegetable production in urban agriculture: A review. Sci. Total Environ. 2020, 698, 134154. [Google Scholar] [CrossRef]
- Xu, B.; Wang, F.; Zhang, Q.; Lan, Q.; Liu, C.; Guo, X.; Cai, Q.; Chen, Y.; Wang, G.; Ding, J. Influence of iron plaque on the uptake and accumulation of chromium by rice (Oryza sativa L.) seedlings: Insights from hydroponic and soil cultivation. Ecotoxicol. Environ. Saf. 2018, 162, 51–58. [Google Scholar] [CrossRef] [PubMed]
Disclaimer/Publisher’s Note: The statements, opinions and data contained in all publications are solely those of the individual author(s) and contributor(s) and not of MDPI and/or the editor(s). MDPI and/or the editor(s) disclaim responsibility for any injury to people or property resulting from any ideas, methods, instructions or products referred to in the content. |
© 2023 by the authors. Licensee MDPI, Basel, Switzerland. This article is an open access article distributed under the terms and conditions of the Creative Commons Attribution (CC BY) license (https://creativecommons.org/licenses/by/4.0/).